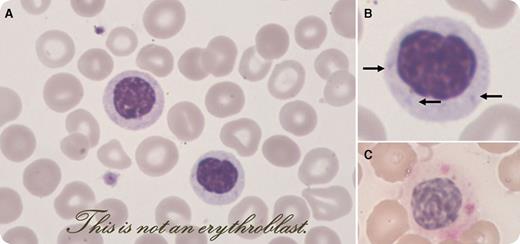
An 82-year-old woman was admitted for diffuse bone pain and deep asthenia. She was receiving erythropoietin for a refractory cytopenia with ring sideroblasts and thrombocytosis diagnosed 14 years before. A diagnosis of acute myeloid leukemia was made because of the presence of 22% myeloid blasts in the peripheral blood smear. We focused our attention on a frequent population (25%) of round-shaped nucleated cells with acidophilic cytoplasm that were identified at first glance as acidophilic erythroblasts (panel A). However, careful examination of these cells showed coarse nuclear chromatin resembling dysplastic polymorphs. Moreover, Döhle bodies were found in some of them (panel B, arrows), and weak myeloperoxidase activity was detectable in most of these cells (panel C). These observations allowed us to identify these cells as pseudo–Pelger-Huët neutrophils, associated with marked hypogranulation. We also used flow cytometry to confirm the absence of erythroblasts with CD36/CD71 staining of living cells. The cytogenetic examination showed a complex karyotype associated with a 17p− deletion, which is associated with small pseudo–Pelger-Huët neutrophils with round nuclei. / This observation illustrates how dysplastic cells might be difficult to recognize and should warn us about “the treachery of images” that René Magritte (1898-1967) highlighted with his famous painting representing a pipe and the inscription “This is not a pipe.”

An 82-year-old woman was admitted for diffuse bone pain and deep asthenia. She was receiving erythropoietin for a refractory cytopenia with ring sideroblasts and thrombocytosis diagnosed 14 years before. A diagnosis of acute myeloid leukemia was made because of the presence of 22% myeloid blasts in the peripheral blood smear. We focused our attention on a frequent population (25%) of round-shaped nucleated cells with acidophilic cytoplasm that were identified at first glance as acidophilic erythroblasts (panel A). However, careful examination of these cells showed coarse nuclear chromatin resembling dysplastic polymorphs. Moreover, Döhle bodies were found in some of them (panel B, arrows), and weak myeloperoxidase activity was detectable in most of these cells (panel C). These observations allowed us to identify these cells as pseudo–Pelger-Huët neutrophils, associated with marked hypogranulation. We also used flow cytometry to confirm the absence of erythroblasts with CD36/CD71 staining of living cells. The cytogenetic examination showed a complex karyotype associated with a 17p− deletion, which is associated with small pseudo–Pelger-Huët neutrophils with round nuclei.
This observation illustrates how dysplastic cells might be difficult to recognize and should warn us about “the treachery of images” that René Magritte (1898-1967) highlighted with his famous painting representing a pipe and the inscription “This is not a pipe.”
An 82-year-old woman was admitted for diffuse bone pain and deep asthenia. She was receiving erythropoietin for a refractory cytopenia with ring sideroblasts and thrombocytosis diagnosed 14 years before. A diagnosis of acute myeloid leukemia was made because of the presence of 22% myeloid blasts in the peripheral blood smear. We focused our attention on a frequent population (25%) of round-shaped nucleated cells with acidophilic cytoplasm that were identified at first glance as acidophilic erythroblasts (panel A). However, careful examination of these cells showed coarse nuclear chromatin resembling dysplastic polymorphs. Moreover, Döhle bodies were found in some of them (panel B, arrows), and weak myeloperoxidase activity was detectable in most of these cells (panel C). These observations allowed us to identify these cells as pseudo–Pelger-Huët neutrophils, associated with marked hypogranulation. We also used flow cytometry to confirm the absence of erythroblasts with CD36/CD71 staining of living cells. The cytogenetic examination showed a complex karyotype associated with a 17p− deletion, which is associated with small pseudo–Pelger-Huët neutrophils with round nuclei.
This observation illustrates how dysplastic cells might be difficult to recognize and should warn us about “the treachery of images” that René Magritte (1898-1967) highlighted with his famous painting representing a pipe and the inscription “This is not a pipe.”
For additional images, visit the ASH IMAGE BANK, a reference and teaching tool that is continually updated with new atlas and case study images. For more information visit http://imagebank.hematology.org.